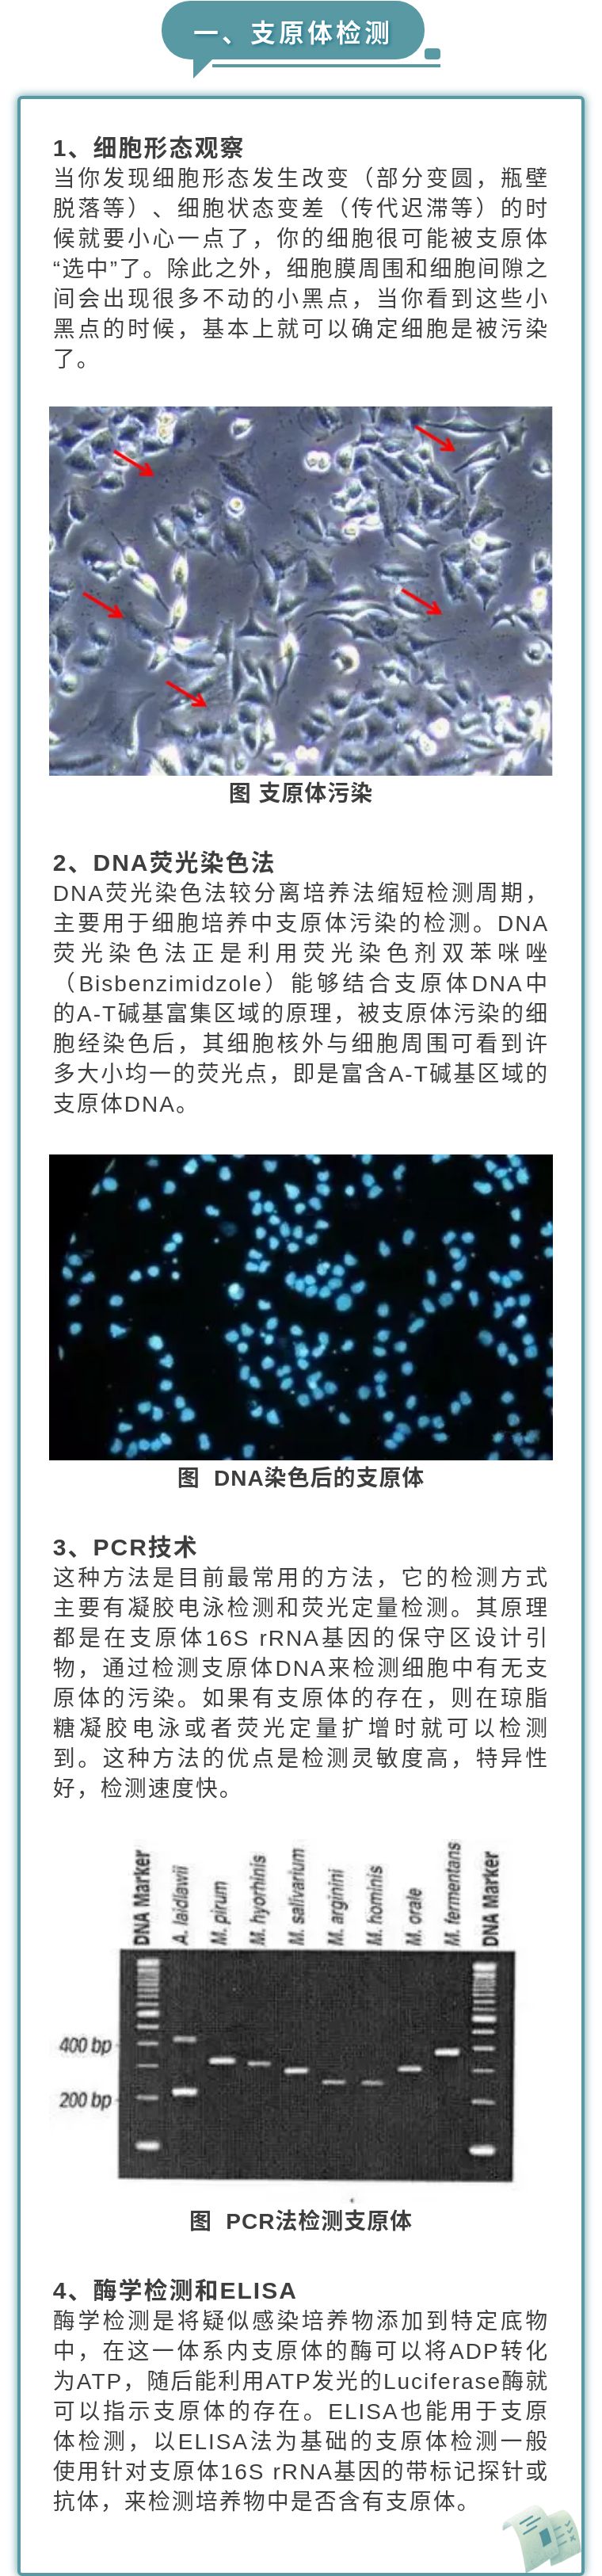

技術服務
Support

Support

電話:4009968872
隨時隨地為您服務
@建諾為生物

©2024 建諾為生物技術(江蘇)有限公司 All Rights Reserved. 蘇ICP備2023046263號-1網站技術支持:勵鎧科技
本網站銷售的所有產品均不得用于人類或動物之臨床診斷或治療,僅可用于工業或者科研等非醫療目的。
<dfn id='a5h4z'><optgroup id='a5h4z'></optgroup></dfn><tfoot id='a5h4z'><bdo id='a5h4z'><div id='a5h4z'></div><i id='a5h4z'><dt id='a5h4z'></dt></i></bdo></tfoot>